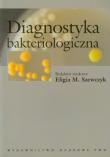
Diagnostyka bakteriologiczna. Wydawca: Wydawnictwo Naukowe PWN. Dadada.pl Opakowanie Diagnostyka bakteriologiczna

Publikacja bogato ilustrowana (ryciny, wykresy, schematy, liczne tabele). Stanowi znakomity podręcznik dla studentów kierunków studiów: biologia, rolnictwo, ogrodnictwo, leśnictwo, ochrona środowiska, biotechnologia, a także dla doktorantów
17% rabatu
21,68 zł
26,25 zł
niedostępny
Najniższa cena z ostatnich 30 dni: 21,68 zł

Hodowla komórek i tkanek
Autor:
Praca zbiorowa
Wydawca:
Wydawnictwo Naukowe PWN
wysyłka: niedostępny
Pierwszy oryginalny podręcznik w języku polskim poświęcony pozaustrojowej hodowli komórek i tkanek. W 29 rozdziałach przedstawiono najnowsze zagadnienia teoretyczne i liczne wskazówki praktyczne, które ułatwią opanowanie tej niełatwej techn
31% rabatu
71,60 zł
104,00 zł
niedostępny
Najniższa cena z ostatnich 30 dni: 71,60 zł

Kolejna książka z serii Krótkie wykłady, przedstawiająca w sposób jasny, przystępny i wyczerpujący stan współczesnej wiedzy w dziedzinie mikrobiologii. Podzielona została na 10 sekcji, w których omówiono:
* świat mikroorganizmów,
* metabo
21% rabatu
46,37 zł
59,00 zł
niedostępny
Najniższa cena z ostatnich 30 dni: 46,37 zł

Krótkie wykłady Biologia rozwoju
Autor:
Twyman R.M.
Wydawca:
Wydawnictwo Naukowe PWN
wysyłka: niedostępny
Książka zawiera ogromną ilość wiadomości na temat rozwoju zarodkowego zwierząt, a zwłaszcza molekularnych mechanizmów kontrolujących poszczególne etapy embriogenezy. Jest także sekcja poświęcona najważniejszym elementom embriologii roślin,
19% rabatu
48,28 zł
59,90 zł
niedostępny
Najniższa cena z ostatnich 30 dni: 48,28 zł

Krótkie wykłady Biologia rozwoju
Autor:
Twyman R.M.
Wydawca:
Wydawnictwo Naukowe PWN
wysyłka: niedostępny
Książka zawiera ogromną ilość wiadomości na temat rozwoju zarodkowego zwierząt, a zwłaszcza molekularnych mechanizmów kontrolujących poszczególne etapy embriogenezy. Jest także sekcja poświęcona najważniejszym elementom embriologii roślin,
19% rabatu
48,28 zł
59,90 zł
niedostępny
Najniższa cena z ostatnich 30 dni: 48,28 zł

Mikrobiologia
Autor:
Salyers Abigail A.
Whitt Dixie D.
Wydawca:
Wydawnictwo Naukowe PWN
wysyłka: niedostępny
Doskonały podręcznik z mikrobiologii – nauki, która ukształtowała i kształtuje współczesny świat!
Nietypowy sposób przedstawiania wiedzy mikrobiologicznej powoduje, że jest to pozycja unikatowa, która uzmysławia znaczenie bakterii dla istni
19% rabatu
79,78 zł
99,00 zł
niedostępny
Najniższa cena z ostatnich 30 dni: 79,78 zł

Mikrobiologia Różnorodność, chorobotwórczość i środowisko
Autor:
Salyers Abigail A.
Whitt Dixie D.
Wydawca:
Wydawnictwo Naukowe PWN
wysyłka: niedostępny
Książka obejmuje:
większość zagadnień mikrobiologii ogólnej;
elementy mikrobiologii lekarskiej;
elementy mikrobiologii weterynaryjnej;
zagadnienia mikrobiologii środowiskowej.
Podręcznik składa się z 4 działów.
Dział 1 opisuje pochodzen
19% rabatu
79,78 zł
99,00 zł
niedostępny
Najniższa cena z ostatnich 30 dni: 79,78 zł

Nowoczesny podręcznik poświęcony dziedzinie, która zajmuje się opisem zjawisk wywołanych przez mikroorganizmy podczas realizacji procesów przemysłowych.
Tom 1 skupia się na opisie morfologii, budowy, ekologii oraz przynależności diagnostyc
19% rabatu
48,28 zł
59,90 zł
niedostępny
Najniższa cena z ostatnich 30 dni: 48,28 zł

W wydaniu tym, tak jak poprzednio, przedstawiono wybrane informacje o fizjologii układu nerwowego człowieka, elementy opisu sieci neuronowych metodami mechaniki statystycznej, właściwości i zastosowania sieci Hopfielda, sieci komórkowych or
25% rabatu
34,02 zł
45,15 zł
niedostępny
Najniższa cena z ostatnich 30 dni: 34,02 zł

W książce przedstawiono jasny i zwięzły obraz procesów fotosyntezy. Zagadnienia tego procesu na poziomie molekularnym zostały omówione na podstawie badań biochemicznych i genetycznych. Przedstawiono także rolę fotosyntezy w produkcji żywnoś
34% rabatu
28,83 zł
44,00 zł
niedostępny
Najniższa cena z ostatnich 30 dni: 28,83 zł

„To najcudowniejsza z map stworzonych dotąd przez ludzkość” – powiedział w 2000 r. prezydent USA Bill Clinton o pierwszym ludzkim genomie odczytanym przez uczonych. Wszyscy spodziewali się wówczas rewolucji w medycynie – nowych, skuteczniej
39% rabatu
12,05 zł
19,90 zł
niedostępny
Najniższa cena z ostatnich 30 dni: 12,05 zł

Publikacja jest zwięzłym przewodnikiem pomocnym lekarzowi w podejmowaniu trudnych decyzji i ułatwiającym orientację w niełatwej problematyce etycznej związanej z wykonywaniem zawodów medycznych i szeroko pojętą działalnością profesjonalną w
19% rabatu
39,49 zł
49,00 zł
niedostępny
Najniższa cena z ostatnich 30 dni: 39,49 zł

Bakterie w organizmie człowieka – sprzymierzeńcy czy agresorzy?
W książce przedstawiono problemy diagnostyki bakteriologicznej uwzględniając 2 aspekty:
* szeroki przegląd bakterii związanych z człowiekiem
podstawy taksonomii bakterii, akt
19% rabatu
40,22 zł
49,90 zł
niedostępny
Najniższa cena z ostatnich 30 dni: 40,22 zł

Pierwszy oryginalny podręcznik w języku polskim poświęcony pozaustrojowej hodowli komórek i tkanek.
W 29 rozdziałach przedstawiono najnowsze zagadnienia teoretyczne i liczne wskazówki praktyczne, które pomogą w opanowaniu tej niełatwej tech
19% rabatu
67,70 zł
84,00 zł
niedostępny
Najniższa cena z ostatnich 30 dni: 67,70 zł

Pierwszy oryginalny podręcznik w języku polskim poświęcony pozaustrojowej hodowli komórek i tkanek.
W 29 rozdziałach przedstawiono najnowsze zagadnienia teoretyczne i liczne wskazówki praktyczne, które ułatwią opanowanie tej niełatwej tech
19% rabatu
67,70 zł
84,00 zł
niedostępny
Najniższa cena z ostatnich 30 dni: 67,70 zł

Niniejsza książka z serii "Krótkie wykłady" zawiera najważniejsze informacje dotyczące mikrobiologii. Wiadomości są przedstawione w skondensowanej, nowoczesnej formie przewodnika. Ma doskonały układ materiału, hasła wprowadzające ułatwiają
19% rabatu
40,22 zł
49,90 zł
niedostępny
Najniższa cena z ostatnich 30 dni: 40,22 zł

Biostymulacja procesów geochemicznych w warunkach beztlenowych w środowiskach glebowych zanieczyszcz
Autor:
Wolicka Dorota
wysyłka: niedostępny
Publikacja z pogranicza geologii i mikrobiologii dotycząca specyficznych interakcji zachodzących na niewielkiej głębokości w litosferze przy udziale biosfery. Autorka opisuje modele przemian przebiegających w środowisku glebowym zanieczyszc
19% rabatu
24,54 zł
30,45 zł
niedostępny
Najniższa cena z ostatnich 30 dni: 24,54 zł

Krótkie wykłady Mikrobiologia
Autor:
Nicklin J.
Graeme-Cook K.
Wydawca:
Wydawnictwo Naukowe PWN
wysyłka: niedostępny
Kolejna książka z serii Krótkie wykłady, przedstawiająca w sposób jasny, przystępny i wyczerpujący stan współczesnej wiedzy w dziedzinie mikrobiologii. Podzielona została na 10 sekcji, w których omówiono:
* świat mikroorganizmów,
* metabo
19% rabatu
40,22 zł
49,90 zł
niedostępny
Najniższa cena z ostatnich 30 dni: 40,22 zł

Postęp, jaki dokonuje się w biotechnologii, stawia nas przed nowymi, trudnymi wyzwaniami moralnymi.Dyskusja nad tymi zagadnieniami ma miejsce nie tylko w gronie specjalistów; obejmuje ona także szerokie kręgi opinii publicznej. Bioetyka dla
38% rabatu
24,84 zł
39,90 zł
niedostępny
Najniższa cena z ostatnich 30 dni: 24,84 zł
Bakterie w organizmie człowieka – sprzymierzeńcy czy agresorzy?
W książce przedstawiono problemy diagnostyki bakteriologicznej uwzględniając 2 aspekty:
* szeroki przegląd bakterii związanych z człowiekiem
podstawy taksonomii bakterii, akt
19% rabatu
40,22 zł
49,90 zł
niedostępny
Najniższa cena z ostatnich 30 dni: 40,22 zł
Liczba wyświetlanych pozycji:
Idź do strony:

Uwaga!!!
Ten produkt jest zapowiedzią. Realizacja Twojego zamówienia ulegnie przez to wydłużeniu do czasu premiery tej pozycji. Czy chcesz dodać ten produkt do koszyka?
TAK
NIE

Wybierz wariant produktu
|
|









